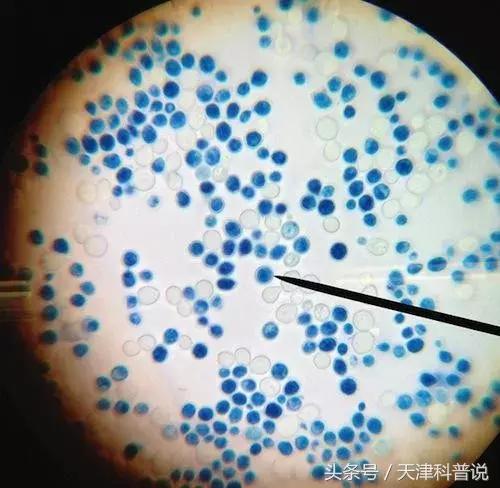
葡萄酒82年拉菲多少价位一瓶,82年拉菲是什么葡萄酒

生活中
很多人都喜欢喝葡萄酒
“来一瓶82年的拉菲”
已经是电影中经典的桥段
葡萄酒当然是由葡萄而来
但是你知道
葡萄是怎么变成葡萄酒的吗?

简单原理
简单来说,葡萄酒的酿造就是酵母菌在无氧环境中将葡萄中的糖分分解成酒精和二氧化碳的过程。
可以简单写成下面这个公式:
酵母 + 糖 = 酒精 + 二氧化碳↑

酵母
分类简介
1
在我们常喝的酿造类葡萄酒中,如果根据葡萄酒的含糖量,可分为干葡萄酒、半干葡萄酒、半甜葡萄酒和甜葡萄酒。
按照我国的标准是每升糖度小于4克的为干型酒,4~12克为半干,12~50克为半甜,50克以上的为甜型酒。
2
如果以葡萄酒的色泽划分。有红葡萄酒、白葡萄酒和玫瑰红葡萄酒。
但是有一点,白葡萄酒并非就是白色的,只是相对于红葡萄酒而言。
红葡萄酒也有多种的红,根据葡萄酒的年龄来定。玫瑰红比红色稍淡,有洋葱皮色,也有浅红色。
在电影中经常见到的“82年的拉菲”,就是一种红葡萄酒,因为产于法国拉菲酒庄而得名,因其花香、果香突出,芳醇柔顺,典雅,称为葡萄酒王国中的皇后。


3
葡萄酒还可以以形态进行划分,按照形态来分有起泡酒和静止酒。
所谓起泡酒,就是会不停冒气泡的葡萄酒,香槟就是起泡酒,但是不要以为起泡酒都可以叫“香槟”。!香槟其实是法国的一个地名,这个地方的起泡酒就叫“香槟”,实在是一种地名保护。
静止酒顾名思义,就是不会冒气泡的酒,如干红和干白都属于静止酒。

酿酒酵母
酵母作为酒精发酵过程中的主力军,进行无氧分解,将葡萄糖分解除了酒精,最后,大多数酵母菌死亡后成为酒泥。在红葡萄酒和部分白葡萄酒的酿造过程中,对死亡的酵母通过工艺进行过滤,以获得更加澄清的葡萄酒。
酵母君牺牲自己,成就了葡萄酒酿造的绝妙工艺。令人不禁想起那句诗:
落红不是无情物
化作春泥更护花
